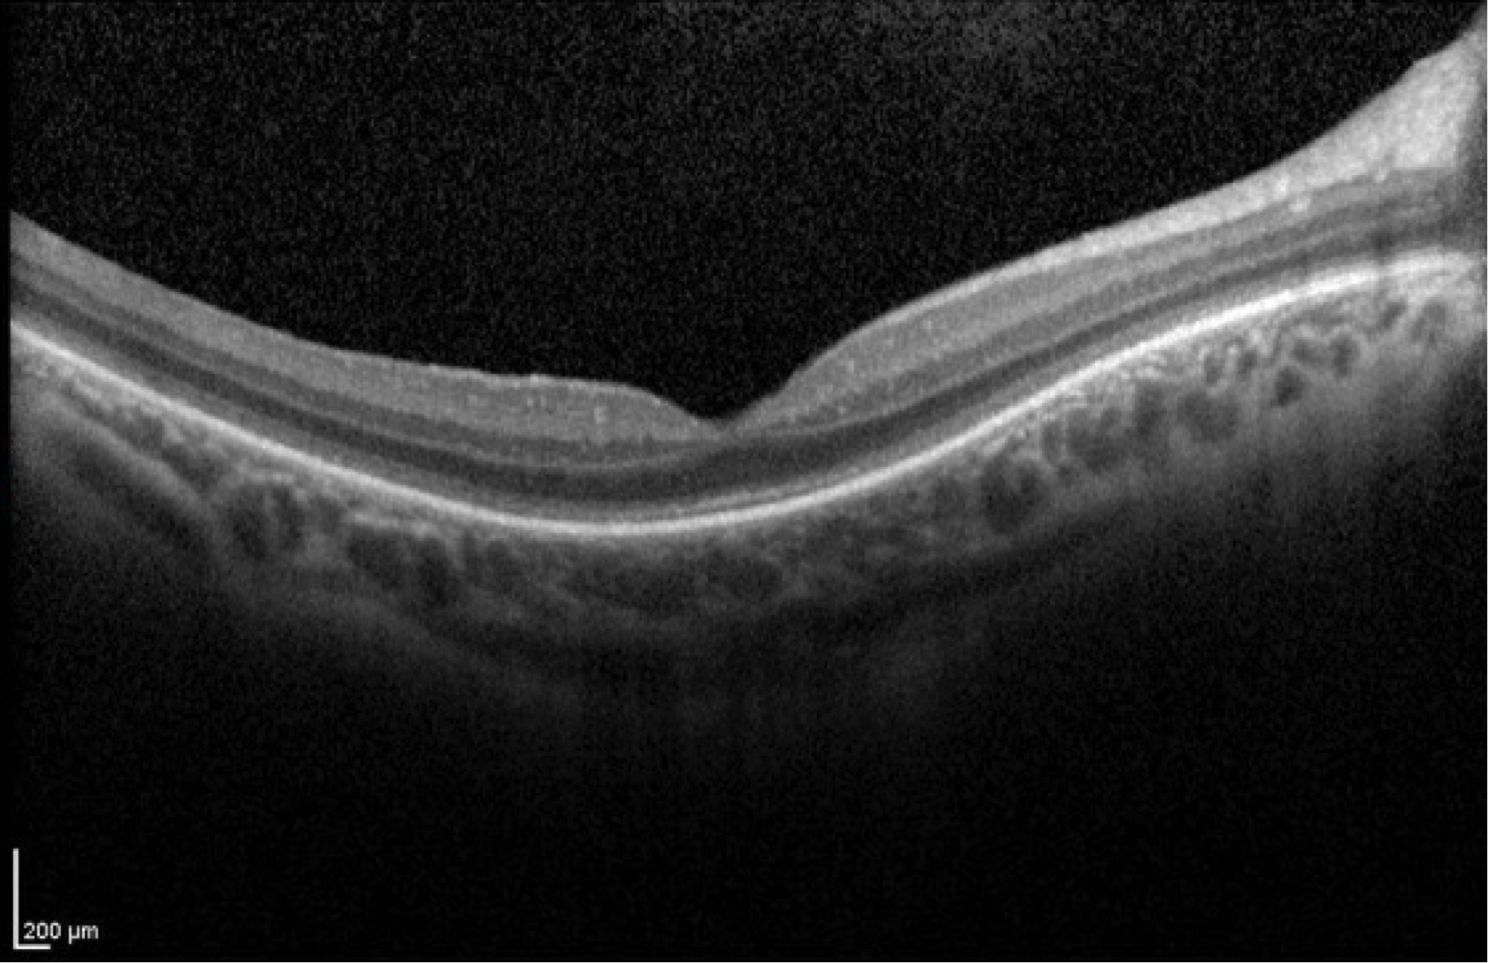

Big 14 Self-Assessment
Case 15
Case 15 is 5 years old and has 20/40 visual acuity. His normally sighted parents noticed that he bumped into things inexplicably shortly after he began to walk. They sought medical attention and he was given hyperopic spectacles of about 4 diopters which seemed to help with his central vision. However, his parents still suspected that his peripheral field was constricted because he would back up to find things. Electroretinography was then performed which revealed reduced scotopic responses and completely extinguished photopic responses. Goldmann perimetry revealed a V4e isopter about 50 degrees in diameter.